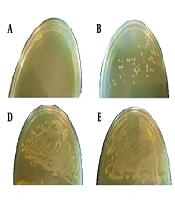
Iran J Pharm Res

IJ Pharmaceutical Research
8
Dec
2025

Research Article
Pin1 as a Central Modulator of Wnt/β-Catenin Signaling in Pulmonary Fibrosis: Interplay with EBV-LMP1 and Therapeutic Implications
Xiaodan Jiao,
Jin Yingli,
Yanchao Liu,
Hong Jiang Yan,
Pei Wang,
Yadong Yuan*
7
Dec
2025

Research Article
Design and Optimization of Chitosan/Montmorillonite Nanoparticle for Sustained Vancomycin Delivery in Peri-implantitis
Shima Esmailzadeh,
Taherehsadat Jafarzadeh*,
Mohammad Moazen
2
Dec
2025

Research Article
Ellagic Acid Ameliorates Diabetic Cardiomyopathy by Inhibiting Ferroptosis Through the Modulation of the SIRT1/p53 Pathway in Streptozotocin-Induced Diabetic Rats
Qingmei Wang,
Xuanguo Zhang,
Li Xi*
27
Nov
2025

Research Article
In vitro Multi-targeted Anti-cancer Effects of Bavachinin in Papillary Thyroid Carcinoma Cell Line: Dual Pathway Inhibition and Cytokine Downregulation
Gang Duan,
Zahra Zahid Piracha,
Umar Saeed,
Yanrong Tian*
18
Nov
2025

Research Article
Effects of Acacetin on the Pharmacokinetics of Diazepam in vivo and in vitro
Ailian Hua,
Li Wang,
Yao Zhu,
Quan Zhou,
Abdullah Al Mamun,
Shuanghu Wang
,et al.17
Nov
2025

16
Nov
2025

11
Nov
2025

Research Article
Biological Activities of Alkaloid Fraction of Fritillaria karelinii (Fisch. ex D. Don)
Ardak Omarbekova,
Sebastian John Adams,
Mamdouh Nabil Samy,
Ubaidilla Datkhayev,
Lashyn Kiyekbayeva*,
Elmira Kapsalyamova
,et al.8
Nov
2025

Review Article
Therapeutic Applications and Target Strategies of Antibody-Drug Conjugates in Ovarian Cancer
Qiming Liu,
Runji Zhou,
Taiqi He,
Yonghong Zhao,
Mei Yang*
24
Oct
2025

Research Article
Combined Omega-3 Fatty Acid and Folic Acid Supplementation Reduces Neonatal Hypoxic-Ischemic Brain Injury via Anti-inflammatory and Anti-apoptotic Mechanisms
Wendong Sun*,
Tanu Ojha,
Vinod Kumar Verma,
Siddhartha Kumar Mishra**
24
Oct
2025

Research Article
Dual Inhibitors of c-MET and EGFR in Triple Negative Breast Cancer: Pharmacophore Modeling and Molecular Dynamics Based in Silico Drug Repositioning
Shadi Abkhiz,
Parastoo Tarighi*,
Homa Azizian**
18
Oct
2025

Systematic Review
Research Progress on the Diagnosis and Treatment of Intestinal Fibrosis in Crohn's Disease with Traditional Chinese and Western Medicine
Qili Xiao,
Delong Mo,
Gang Liu,
Yuting Xu,
Yan Chen*,
Chuanjian Lu**
15
Oct
2025

12
Oct
2025

Systematic Review
Isoliquiritigenin in Breast Cancer: A Systematic Review of Its Preventive and Anti-metastatic Mechanisms
Yuan Xue,
Mingjun Wang*
1
Oct
2025

Research Article
Geranyl Acetate Attenuates Para-phenylenediamine-induced Cytotoxicity, DNA Damage, Apoptosis, and Inflammation in HaCaT Keratinocytes
Jae Ho Lee,
Sungkwan An,
Seokmuk Park*,
Seunghee Bae**
21
Sep
2025

16
Sep
2025

Research Article
Mitigation of Cerebral Ischemia-Reperfusion Injury in Rat by Phellopterin via Antioxidant and Anti-inflammatory Mechanisms
Huici Wang*,
Huan Wang
15
Sep
2025
Research Article
Multi-omics Identify the Role of FGF7 Pathway in Diabetic Foot Ulcers
Wenkang Luan,
Shujun Fan,
Dongwen Jiang,
Leren He*
13
Sep
2025

Research Article
In Silico Analysis of Tat Exons to Increase the Efficacy of a Nef-Tat-based HIV-1 Vaccine Candidate
Leila Sadeghi,
Fatemeh Heidarnejad,
Azam Bolhassani*,
Elham Mohit**,
Parisa Moradi Pordanjani
3
Sep
2025

Research Article
Integrating Network Pharmacology and Experimental Validation to Identifying Key Herbal Components and Targets for Liver Cancer
Fang Wang,
Shenghao Li,
Xiling Liu,
Yi Xu,
Huimin Yan*
25
Aug
2025

16
Aug
2025

Research Article
Elucidating the Inhibitory Potential of Statins Against Oncogenic c-Met Tyrosine Kinase Through Computational and Cell-based Studies
Elham Ahmad Alizadeh,
Leila Karami,
Fahimeh Ghasemi,
Amir Shadboorestan,
Mohammad Reza Torabi,
Vahideh Montazeri
,et al.3
Aug
2025

28
Jul
2025

Research Article
Chronic Pseudomonas aeruginosa Pneumonia Triggers Inflammation-Driven Oncogenic Signaling in Juvenile Mice: Implications for Pharmacological Intervention
Jing Zhang,
Zahra Zahid Piracha,
Umar Saeed,
Dilber Uzun Ozsahin,
Muhammad Waseem,
Yale Zhang*
27
Jul
2025

Research Article
Evaluation of the Rational Use of Broad-Spectrum Antibiotics According to Regulatory Guidelines in Hospitalized Patients: A Descriptive Study
Alireza Kananinambani,
Majid Shohrati*,
Mahdi Bagheri,
Bita Najafian
26
Jul
2025

Research Article
Schisanhenol Alleviates Mycophenolic Acid-Induced Intestinal Epithelial Cell Barrier Damage by Activating the Nrf2/HO-1 Signaling Pathway
Yiyun Deng,
Jiawang Fan,
Chunlan Yang,
Yan Huang,
Qingrong Xia,
Jun Liang
,et al.16
Jul
2025

Research Article
Effect of Diamorphine on Spatial Learning and Memory and Mitochondrial Function of Male Rat Brain
Ainaz Moshtagh,
Maryam Mehdizadeh,
Ghodsieh Hosseinifakhr,
Alireza Foroumadi,
Maryam Baeeri,
Shokoufeh Hassani
,et al.13
Jul
2025

Research Article
Anti-tumor Effects of Hedyotis diffusa Willd on Cervical Cancer: Inhibition of Proliferation, Migration, and Induction of Apoptosis
Siyu Yang,
Lizhu Zeng,
Caiyun Deng,
Xianglian Tian,
Wenkui Sun,
Chengjie Ji*
,et al.25
May
2025

20
May
2025

Research Article
Resveratrol Alleviates Cognitive Impairment in Chronic Cerebral Hypoperfusion by Targeting Lingo-1, NgR1, p75, and RhoA/ROCK-2 Pathways
Mohabbat Jamhiri,
Fatemeh Safari,
Jalil Alizadeh Ghalenoei,
Fatemeh Zare Mehrjerdi*,
Mansoureh Eslami**
14
Apr
2025

Research Article
Investigation of the Antioxidant and Cellular Toxicity Activities of Gold Nanoparticles Synthesized Using Cichorium intybus Extract on a Liver Cancer Cell Line
Mohammad Mohammad-Alizadeh,
Ahmad Asgharzadeh*,
Maryam Tatari
13
Apr
2025

Research Article
Study on the Role of Schisandrin B in Ameliorating Hepatic Ischemia-Reperfusion Injury by Modulating Hepatocyte Autophagy
Zhao Fei,
Pan Haihang,
Chen Xueyang,
Shen Miao*
26
Mar
2025

Research Article
Antimicrobial, Anti-inflammatory, Angiogenesis, and Wound Healing Activities of Copper Nanoparticles Green Synthesized by Lupinus arcticus Extract
Nizar H. Saeedi*,
Abdullah D. Alanazi,
Rawaf Alenazy,
Abdullah F. Shater
8
Mar
2025

Research Article
KMT2D Induces M1 Macrophage Polarization to Repress Non-small Cell Lung Cancer Progression via Transcription Activation of ITGAL
Wen-Tao Wang,
Jie Yang,
Peng-Fei Jiang*
8
Mar
2025

Research Article
Neuroprotective Effects of Early TLR4 Blockade with Compound C34 in Temporal Lobe Epilepsy: Alleviation of Neuroinflammation and Apoptosis
Roya Varmazyar,
Nima Naderi,
Hanieh Javid,
Rasoul Ghasemi,
Hamid Gholami Pourbadie*
2
Mar
2025

Research Article
Design, Synthesis, Anticonvulsant Evaluation, and Molecular Docking Studies of New GABAA Agonist Derivatives
Mansur Nassiri Koopaei,
Parsa Moghimirad,
Ebrahim Saeedian Moghadam,
Nasrin Nassiri Koopaei,
Massoud Amanlou,
Tahmineh Akbarzadeh
,et al.2
Mar
2025

11
Feb
2025

Research Article
Perioperative Use of Pregabalin vs. Duloxetine for Pain Management of Knee Fracture Surgery: A Double-Blind Randomized Clinical Trial
Mohadeseh Masoumi,
Mohammad Soleimani,
Tara Shekari,
Maryam Alaei,
Mehrdad Sheikhvatan,
Mojtaba Mojtahedzadeh
,et al.29
Jan
2025
9
Dec
2025